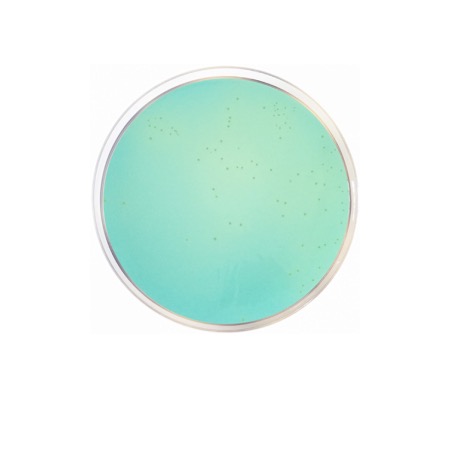
product
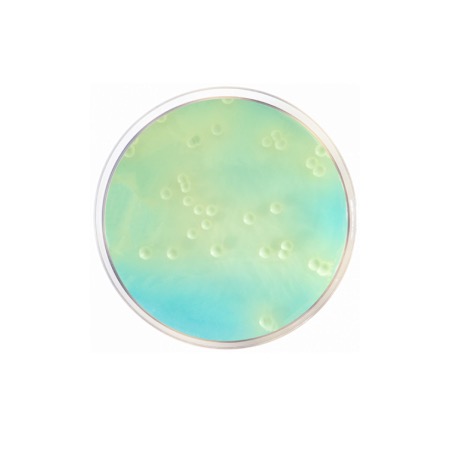
product

WL Nutrient Broth is formulated to provide a nutrient-rich liquid environment that mirrors the conditions found in fermentation mashes and juices. The Casein Peptone and Yeast Extract serve as the primary sources of nitrogen, amino acids, and essential vitamins. A high concentration of Glucose acts as the energy source for the metabolism of both fermenting yeasts (such as Saccharomyces) and potential bacterial contaminants. The medium is balanced with an extensive mineral profile including Monopotassium Phosphate, Potassium Chloride, Calcium Chloride, Magnesium Sulfate, and trace amounts of Ferric Chloride and Manganese Sulfate, which act as vital cofactors. The inclusion of Bromocresol Green serves as a pH indicator; as organisms grow and ferment the glucose, the production of acid causes the broth to shift from blue-green to yellow, providing a visual cue of microbial activity.
Advantages
- Total Flora Enrichment: Supports the growth of a wide spectrum of microorganisms, providing a complete picture of the microbial population in a fermentation system.
- Versatile Liquid Format: Ideal for use in enrichment protocols, beverage testing, or as a base for specialized fermentation studies.
- Metabolic Monitoring: The Bromocresol Green indicator allows for the rapid visual detection of acid-producing contaminants (such as Lactobacillus or Acetobacter).
- Optimized Mineral Content: Specifically designed to meet the unique enzymatic requirements of organisms adapted to industrial fermentation environments.
- Industry Standard: Part of the Wallerstein Laboratory suite of media, globally recognized for quality control in brewing, winemaking, and distilling.
Technical specifications
| Catalogue number |
1572 |
| Brand |
Condalab |
| Application |
Cultivation and enrichment of fermentation flora (Total Count) |
| Typical Composition (g/L) |
Glucose (50.0); Casein Peptone (5.0); Yeast Extract (4.0); Monopotassium Phosphate (0.55); Potassium Chloride (0.425); Calcium Chloride (0.125); Magnesium Sulfate (0.125); Ferric Chloride (0.0025); Manganese Sulfate (0.0025); Bromocresol Green (0.022) |
| Final pH (at 25 °C) |
5.5 ± 0.2 |
| Preparation |
60.25 g/L |
| Storage Temperature |
2 – 25 °C |
Available packaging options
| 1572 |
500 g plastic bottle |